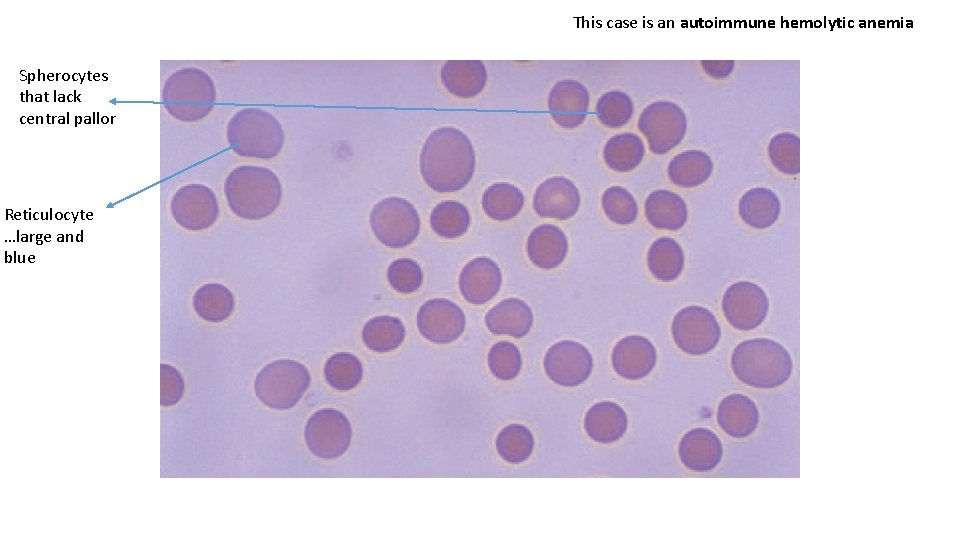
This case is an autoimmune hemolytic anemia Spherocytes that lack central pallor Reticulocyte …large
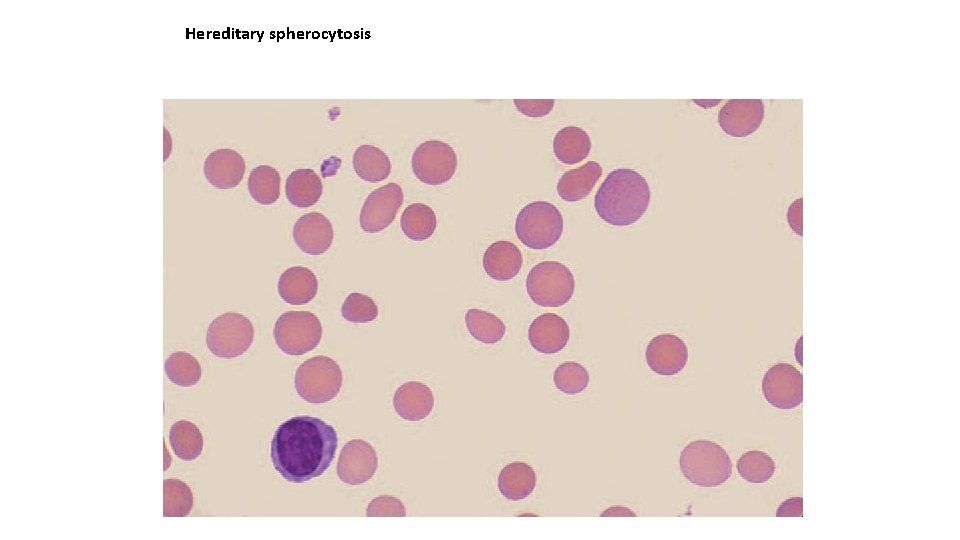
Hereditary spherocytosis
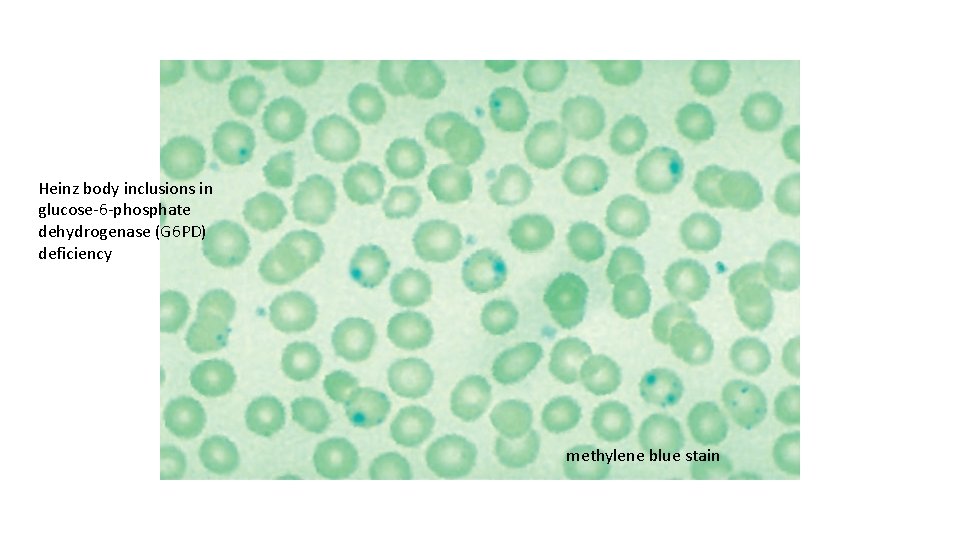
Heinz body inclusions in glucose-6 -phosphate dehydrogenase (G 6 PD) deficiency methylene blue stain
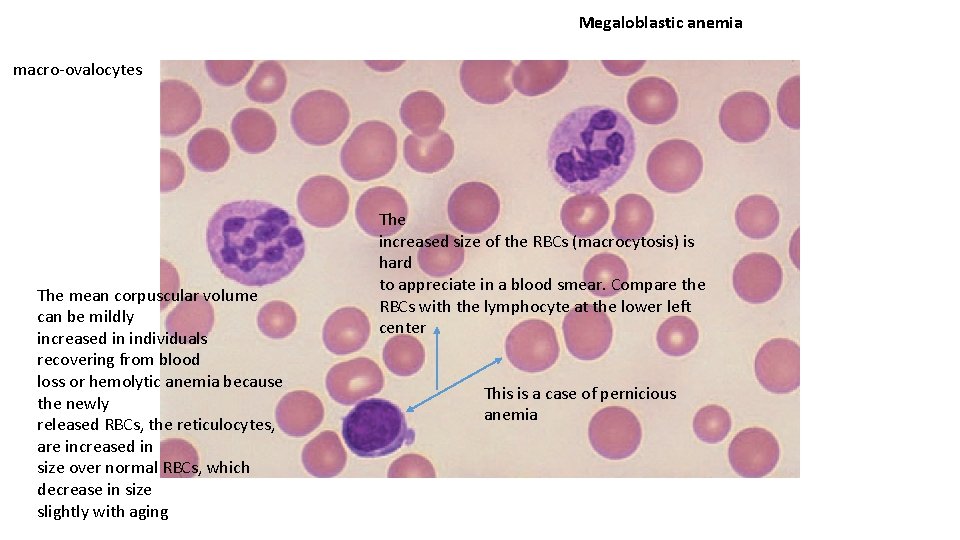
Megaloblastic anemia macro-ovalocytes The mean corpuscular volume can be mildly increased in individuals recovering
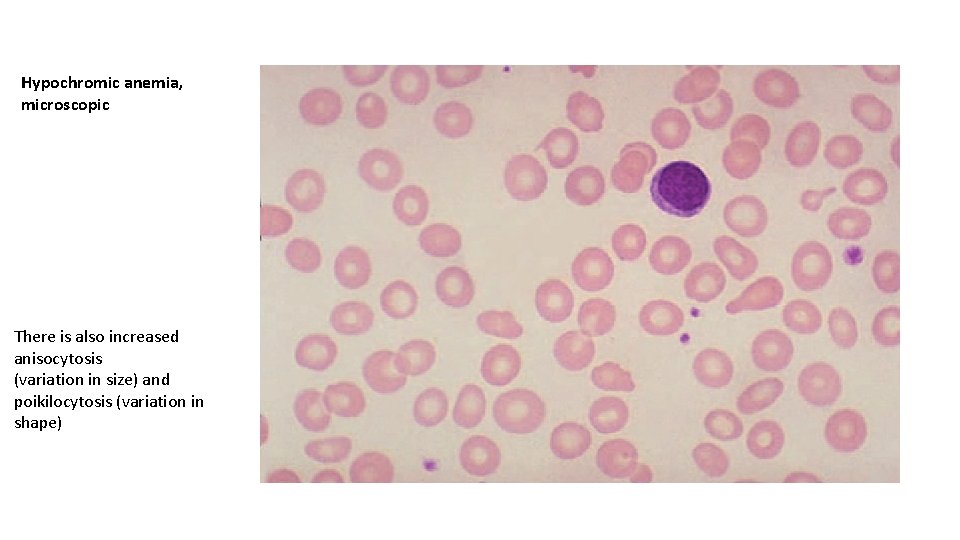
Hypochromic anemia, microscopic There is also increased anisocytosis (variation in size) and poikilocytosis (variation
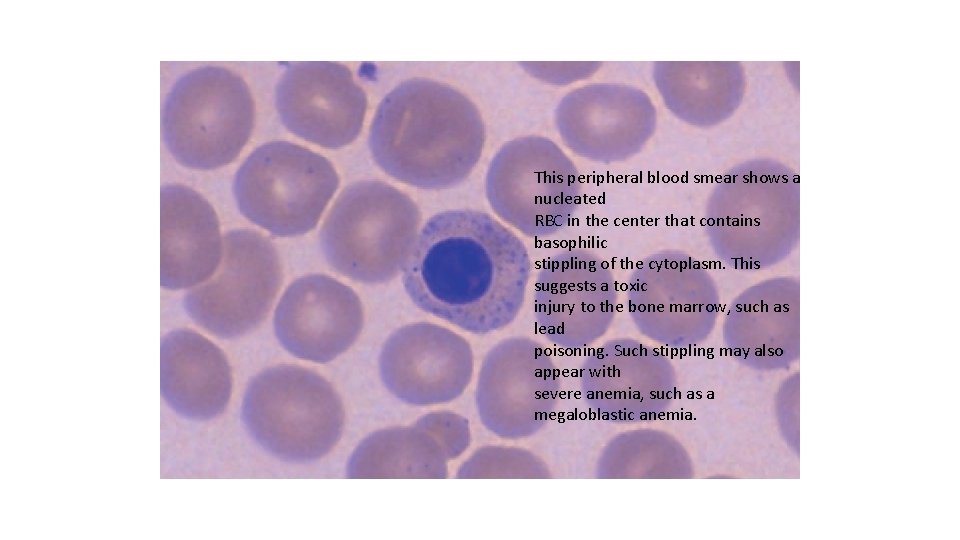
This peripheral blood smear shows a nucleated RBC in the center that contains basophilic
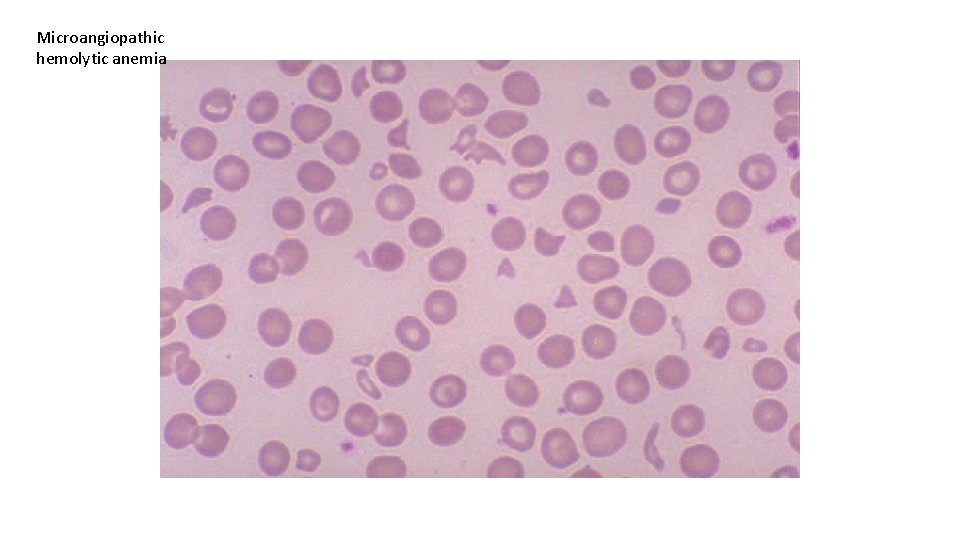
Microangiopathic hemolytic anemia
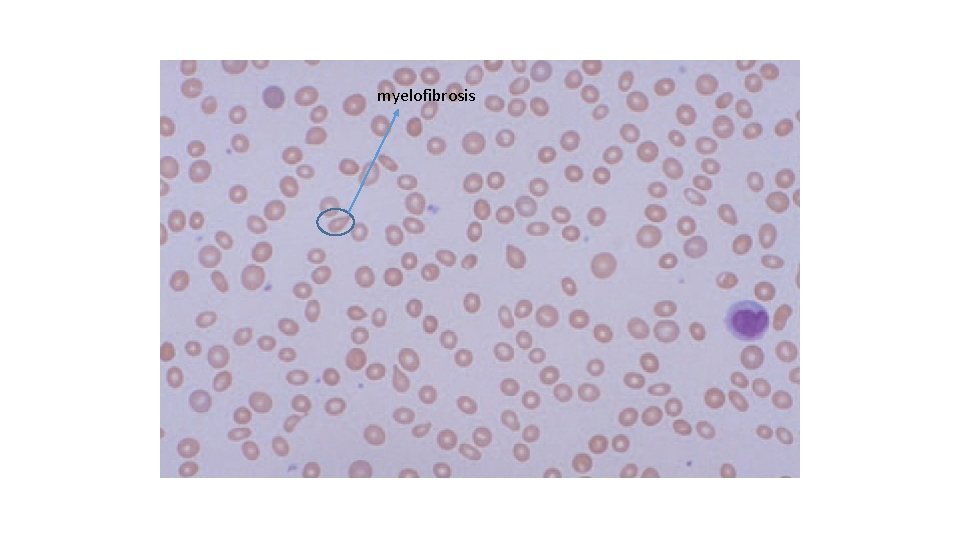
myelofibrosis

Normal blood film a zone of central pallor

Normal blood film a zone of central pallor about one third the size of the RBC diameter Platelet (small and Blue-staining) An RBC is about two thirds the size of a normal lymphocyte Normal mature lymphocyte minimal variation in size (anisocytosis) and shape (poikilocytosis)
This case is an autoimmune hemolytic anemia Spherocytes that lack central pallor Reticulocyte …large and blue
Hereditary spherocytosis
Heinz body inclusions in glucose-6 -phosphate dehydrogenase (G 6 PD) deficiency methylene blue stain

Sickle cell anemia
Megaloblastic anemia macro-ovalocytes The mean corpuscular volume can be mildly increased in individuals recovering from blood loss or hemolytic anemia because the newly released RBCs, the reticulocytes, are increased in size over normal RBCs, which decrease in size slightly with aging The increased size of the RBCs (macrocytosis) is hard to appreciate in a blood smear. Compare the RBCs with the lymphocyte at the lower left center This is a case of pernicious anemia
Hypochromic anemia, microscopic There is also increased anisocytosis (variation in size) and poikilocytosis (variation in shape)
This peripheral blood smear shows a nucleated RBC in the center that contains basophilic stippling of the cytoplasm. This suggests a toxic injury to the bone marrow, such as lead poisoning. Such stippling may also appear with severe anemia, such as a megaloblastic anemia.
Microangiopathic hemolytic anemia
myelofibrosis

AML…acute promyelocytic leukemia Auer rods







AML





Thank you
- Slides: 23